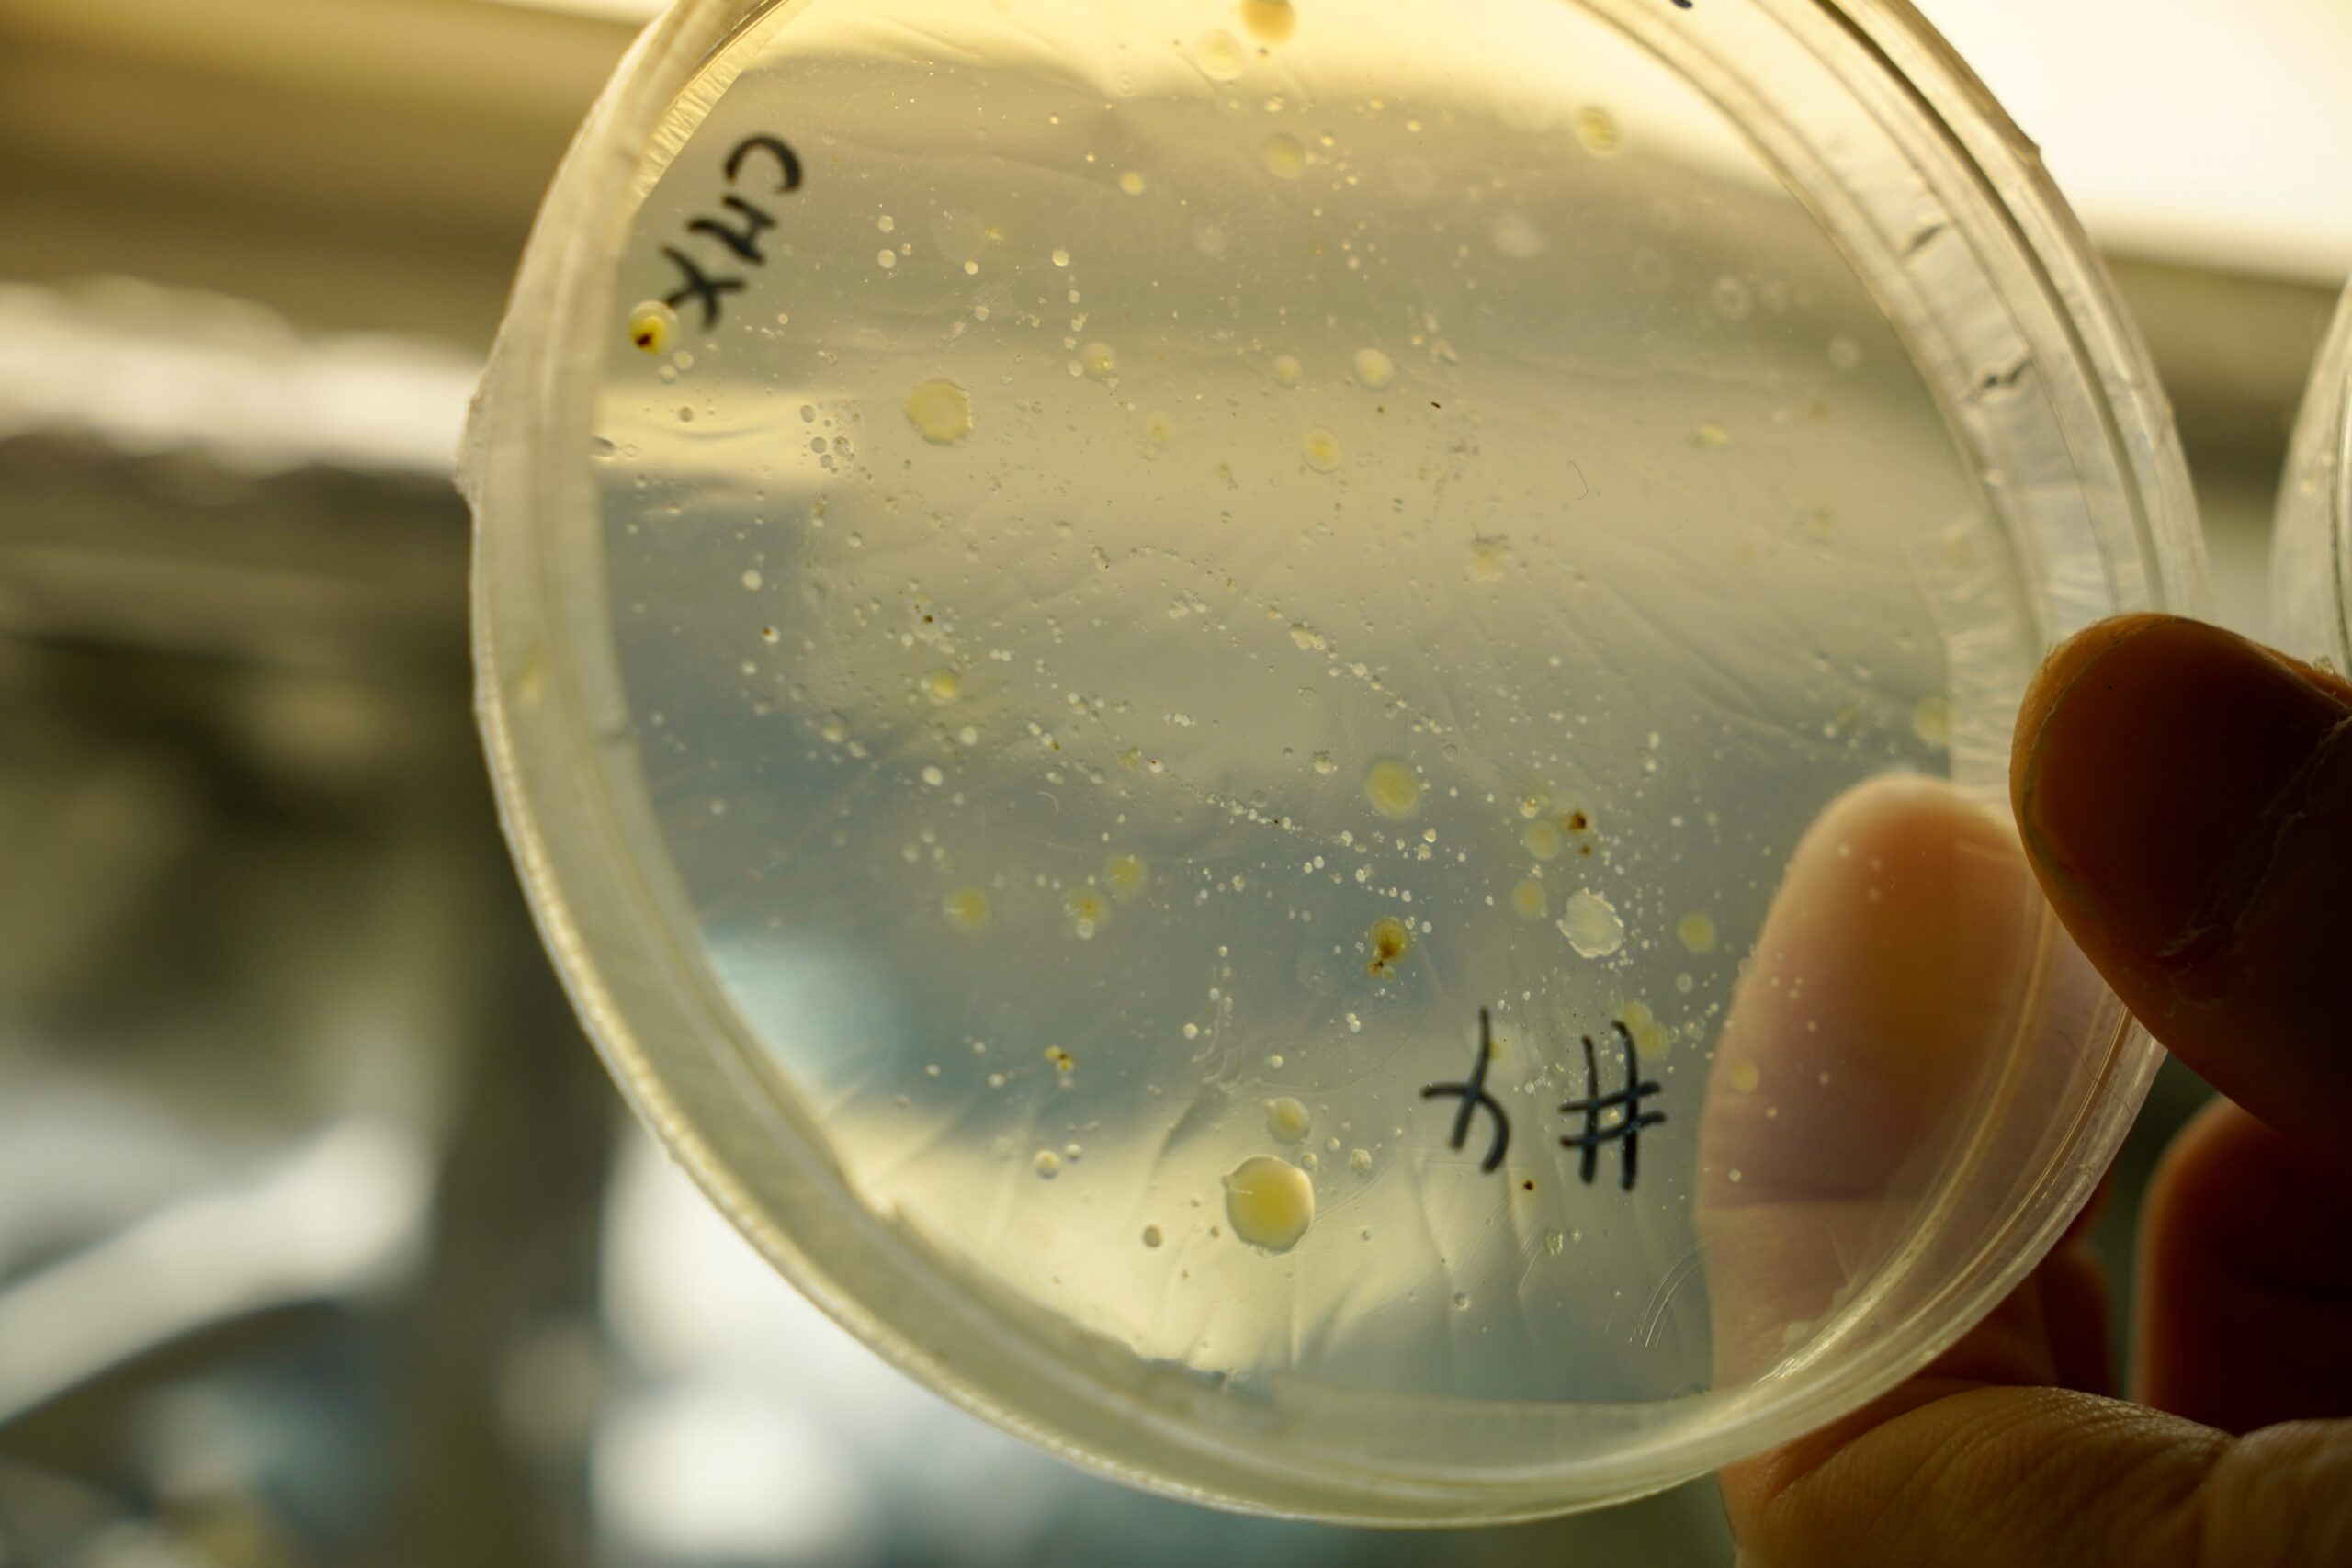

A Tokyo, metaPhorest met en lumière la bioflore chimérique urbaine
Publié le 7 avril 2026 par Cherise Fong
Pendant quelques jours cet hiver, metaPhorest nous a fait voir et entendre les communautés microscopiques qui habitent l’un des cours d’eau les plus urbains de Tokyo. Hideo Iwasaki, directeur de metaPhorest, nous raconte les méthodologies et les révélations de « Silent Neighbors », leur exposition in situ sur la rivière Shibuyagawa.
Depuis les quais de la gare ferroviaire de Shibuya, prenez la sortie New South Gate. Tournez à gauche, traversez la passerelle piétonne au-dessus des voies ferrées, descendez d’un étage par l’escalator, puis empruntez le grand escalier jusqu’au rez-de-chaussée.
Bienvenue à Shibuya Stream, un complexe commercial relativement récent qui comprend une allée principale animée de restaurants et de cafés, directement reliée à la gare tentaculaire de Shibuya et à la tour commerciale de Scramble Square, sans oublier un hôtel de luxe et le siège social de Google Japon.
En contrebas, à deux pas du chaos du célèbre carrefour Shibuya Crossing, se trouve l’artère naturelle du quartier depuis l’époque d’Edo : un étroit cours d’eau qui s’écoule vers le sud-est à travers plusieurs quartiers avant de se jeter dans la baie de Tokyo.

Il s’agit de la rivière Shibuyagawa, dont l’histoire remonte aux temps anciens. Mais à partir de la fin du XIXe siècle, cette rivière naturelle a été de plus en plus aménagée, rétrécie et bordée de béton. Au XXe siècle, elle était davantage considérée comme un canal de drainage autour de la gare de Shibuya, polluée par les déchets industriels et ménagers. Et à l’époque où Tokyo connaissait son apogée de croissance d’après-guerre, de larges tronçons de la Shibuyagawa ont été entièrement recouverts de béton et transformés en canaux souterrains.
Aujourd’hui encore, une grande partie des 2,4 kilomètres de cette rivière fantôme reste entièrement invisible. C’est depuis seulement une vingtaine d’années que la ville s’est efforcée de la nettoyer (elle est officiellement nettoyée tous les quelques mois) et, plus récemment, de revitaliser la section à ciel ouvert entre les gares de Shibuya et d’Ebisu pour en faire une promenade urbaine.
Qui aurait imaginé que la Shibuyagawa abrite également des écosystèmes vivants au niveau microscopique ?
Nos voisins silencieux
Dans le cadre de Dig Shibuya 2026, un événement annuel d’un week-end visant à promouvoir les zones commerciales autour de la gare de Shibuya, le collectif de bioart metaPhorest a eu carte blanche pour créer une exposition in situ à Shibuya Stream. Naturellement, ils se sont intéressés à la rivière.

« C’est une rivière à l’apparence très artificielle, avance Hideo Iwasaki, professeur à l’université de Waseda et directeur de metaPhorest. Mais nous nous sommes toujours intéressés aux systèmes biologiques. Nous avons donc porté notre attention sur les types de biodiversité qui se reconstituent dans une telle région artificielle. Dès le premier jour où nous avons commencé à étudier la composition de la rivière, nous avons constaté qu’elle était vraiment riche en biodiversité – en particulier en algues, ou en combinaisons de bactéries. »
Au cours de l’année, Hideo Iwasaki et cinq autres membres de l’équipe issue de metaPhorest – Tomoki Matsumura, Akira Fujioka, Hanna Saito, Toru Nakajima et Tomoya Ishibashi – ont élaboré le projet Silent Neighbors afin de « rencontrer les êtres qui habitent la Shibuyagawa ».
En parallèle, la Tokyu Corporation, propriétaire et gérante de Shibuya Stream, a mené de longues négociations avec le Bureau des eaux de Shibuya Ward pour se mettre d’accord sur un juste compromis entre des installations high-tech inspirées par l’histoire du lieu et des préoccupations bureaucratiques quant à la sécurité du matériel en extérieur et aux conditions météorologiques.
La bioflore chimérique
Sur le terrain, une des premières surprises de l’équipe de biologistes a été le monde dynamique de la flore chimérique révélé par des images vidéo capturées sous l’eau. Ces images ont dévoilé une véritable forêt de diatomées filamenteuses – des algues unicellulaires jaunâtres dotées d’une coquille vitreuse composée de silicium, qui s’associent au béton et servent de nourriture aux larves de chironomes (Chironomidae). Les moucherons adultes, qui ne piquent pas, contribuent à leur tour au recyclage des nutriments et sont mangés par les oiseaux. Et sous la forêt de diatomées parsemée de morceaux de papier blanc, se trouve une autre couche d’algues vertes (Ulothrix).


« Bien sûr, on pourrait y voir quelque chose de très sale, mais pour moi, c’est vraiment frappant et vif, comme une colonie de petits animaux, observe Iwasaki. J’ai été très surpris et impressionné. D’un point de vue scientifique, c’est également très intéressant de voir comment ce type de structure a émergé, les informations sur les motifs des systèmes biologiques, et comment la population naturelle s’est combinée avec nos artefacts humains pour produire une structure aussi étrange. »
Pour l’exposition Silent Neighbors, metaPhorest a projeté des images aussi bien microscopiques que macroscopiques de cette forêt de diatomées sur des écrans géants tendus au-dessus de la rivière : une superposition surréaliste de mondes coexistants juste au-dessus et au-dessous de la surface de l’eau.

Tomoya Ishibashi s’est également plongé dans la rivière pour voir ce qu’il pouvait y récupérer. Outre divers gadgets, des piles et un couteau, il a trouvé un pied de microphone en métal, une chaîne de vélo et des crampons de bottes à semelles compensées, qu’il a intégrés à sa sculpture finale.

Mais le joyau de son butin était un iPhone cassé dont l’objectif de la caméra était encore intact. S’inspirant d’un concept qu’il avait d’abord expérimenté dans la rivière Arakawa au nord de Tokyo, Ishibashi a modifié et amélioré le système d’objectif du smartphone pour en faire un microscope DIY, qu’il a ensuite utilisé pour observer les micro-organismes présents dans la rivière. Cet outil de fortune a effectivement permis d’agrandir une scène fascinante dans un échantillon d’eau de la Shibuyagawa placé sur une lame de verre, la rendant visible à l’œil nu.
À côté de la boîte transparente exposant le magnifique smartphone-microscope détourné d’Ishibashi, Silent Neighbors a présenté un court métrage qui documente la méthodologie du bioartiste bricoleur. Il se termine par des images étonnantes d’une larve de moucheron se nourrissant d’une diatomée dans son environnement naturel.

Écologies microbiennes urbaines
Au total, les membres de metaPhorest ont prélevé des échantillons sur 13 sites différents le long de la Shibuyagawa, avec pour mission d’analyser et de mettre en lumière ses divers écosystèmes résidents. En adoptant pour Silent Neighbors une approche scientifique, Iwasaki a posé une question précise : « La combinaison d’algues et d’une forte concentration d’objets artificiels favorise-t-elle une forme particulière de biodiversité microbienne ? »

metaPhorest a donc collaboré avec Biota, une entreprise japonaise spécialisée dans l’analyse métagénomique, afin de comparer l’ADN des bactéries vivant dans des zones riches en débris organiques à celui des bactéries vivant dans des zones relativement exemptes de débris. L’analyse de l’ADN a révélé des communautés microbiennes très distinctes. Les zones riches en artefacts abritaient une gamme beaucoup plus large de bactéries particulières : des bactéries anaérobies et fermentatives, des bactéries métabolisant le soufre, des bactéries sporulées, ainsi que des bactéries qui se nourrissent d’autres bactéries.

L’augmentation notable de ces types particuliers de bactéries était une autre surprise pour l’équipe. Bien qu’elles semblent être caractéristiques des rivières urbaines, Iwasaki remarque : « La présence de bactéries supplémentaires montre que le domaine plus artificiel est bien plus complexe. Et comme il est plus riche en bactéries anaérobies, cela signifie probablement que, localement, des conditions anaérobies se produisent dans ces structures chimériques riches en artefacts. »
Les esprits des revêtements
Dans un autre temps, les populations bactériennes des échantillons prélevés dans les différents canaux de drainage le long de la rivière étaient complètement différentes, en représentant les conditions à l’air libre des canalisations. Même à un niveau macro, chacune semble exprimer une personnalité unique, affichant visiblement des couleurs différentes, dans un spectre allant de la rouille riche en fer au vert chlorophyllien.

Au cours de l’exposition, certaines canalisations étaient éclairées pendant la nuit. metaPhorest les a baptisés avec humour « Revetment Spirits » (les esprits des berges), car avec un peu d’imagination, l’aura de leur silhouette vaguement anthropomorphe rappelle celle d’un saint occidental ou d’un moine bouddhiste.
Cependant, Iwasaki est également conscient que certaines personnes pourraient se rappeler un aspect plus grave de l’histoire de la Shibuyagawa : alors que Tokyo était lourdement bombardée pendant la Seconde Guerre mondiale, de nombreuses personnes blessées se sont jetées dans la rivière, où elles sont mortes.
L’analyse ADN des échantillons provenant des canaux de drainage est en cours. Après avoir déterminé leur composition bactérienne respective, Iwasaki prévoit d’utiliser la biologie synthétique pour faire revivre les esprits, ou du moins quelque chose qui leur ressemble.
« Si l’on comprend le principe ou les mécanismes de formation des motifs et que l’on modifie les paramètres, on peut régénérer des motifs légèrement différents, afin de représenter différents types d’esprits, explique-t-il. L’idée initiale était qu’une couleur similaire représentait une composition bactérienne similaire. Mais en réalité, la composition est assez différente, ce n’est donc pas si simple… Nous avons encore beaucoup à apprendre des esprits. »
Métaphores silencieuses
Alors que de nombreux projets d’art urbain contemporain abordent l’écologie environnementale sous un angle militant, la perspective de metaPhorest est plus résolument poétique. Iwasaki nous invite simplement « à regarder sous la surface pour voir ces êtres vivants, à écouter l’individualité de ces créatures ». C’est ainsi que nos « voisins silencieux » prospèrent au milieu de la cacophonie qui règne autour de la gare de Shibuya.
« En général, on ne peut pas entendre leurs voix, explique Iwasaki. La voix est une métaphore de l’individualité. Quelle est la différence entre la voix et le son ? C’est le fait de présupposer ou non la présence de l’individualité. On ne peut pas imaginer la voix sans individualité. Ce projet est donc une fenêtre permettant de voir l’individualité des organismes. »

À propos de metaPhorest : « La métaphore n’est qu’une fenêtre permettant de voir différemment. C’est une manière très importante et intéressante d’aborder des questions complexes. Les métaphores peuvent relier des choses différentes. Bien sûr, scientifiquement, ce n’est pas toujours très utile, mais l’équilibre ambigu entre le risque et la richesse (de la découverte) est en soi une métaphore. »
En savoir plus sur metaPhorest
